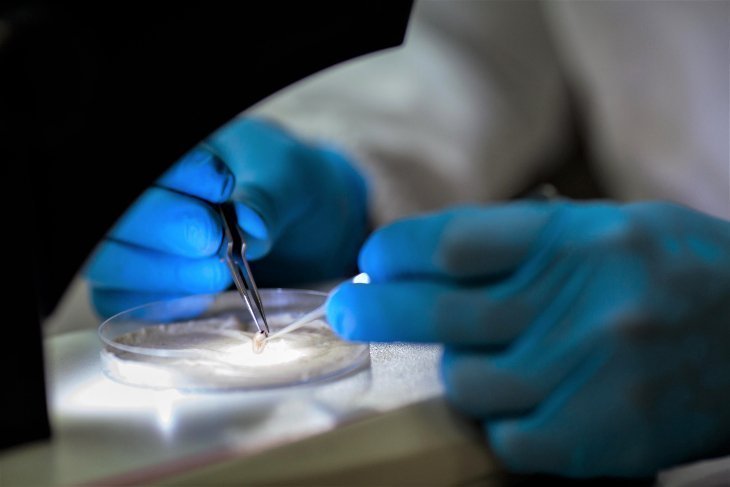
En el laboratorio de investigaciones de ciencias de la salud se realizan actividades de biología molecular con fines académicos e investigativos.

UPB integra red de laboratorios que fortalece capacidades ante crisis sanitaria
Agencia de Noticias UPB - Medellín. En respuesta a la emergencia, Antioquia consolidó una alianza para atender las problemáticas asociadas al virus COVID-19 y otros agentes biológicos de alto riesgo.

La Universidad Pontificia Bolivariana, junto a otras 9 universidades, 2 centros de investigación y desarrollo tecnológico, una institución prestadora de servicios de salud y el Laboratorio Departamental de Salud Pública, establecieron una red de trabajo con el objetivo de mejorar la infraestructura y el equipamiento de sus laboratorios, y, de esta manera, dar respuesta eficaz y oportuna a la pandemia de COVID-19 y a otras situaciones que se puedan presentar por causa de agentes biológicos de alto riesgo.
La idea es prepararse con los niveles de bioseguridad que posibiliten el diagnóstico masivo y adecuado de microorganismos perjudiciales para las personas.
Para lograrlo, cada integrante de la red definió sus principales necesidades en cuanto a talento humano, tecnologías, métodos, procesos y espacios físicos. Información que sirvió para determinar un presupuesto general, a 12 meses, que fue presentado a Minciencias en el marco de la convocatoria del fondo de Ciencia, Tecnología e Innovación del Sistema General de Regalías para el fortalecimiento de laboratorios regionales con potencial de prestar servicios científicos y tecnológicos para atender problemáticas asociadas con agentes biológicos de alto riesgo para la salud humana, con un monto indicativo para Antioquia de veinte mil millones de pesos. De aprobarse este proyecto, en el departamento se formalizaría esta potente Red de Laboratorios Regionales.
En este contexto, la Universidad Pontificia Bolivariana adecuará su laboratorio de investigaciones de la Escuela de Ciencias de la Salud hacia una línea de investigación y servicios denominada: Biovigilancia de enfermedades infecciosas, con el fin de cumplir con las condiciones de habilitación determinadas por el Ministerio de Salud y Protección Social de Colombia para la aplicación de pruebas de diagnóstico molecular.
De acuerdo con el líder de laboratorios y asuntos experimentales de la Universidad, José Isaac Jaramillo Moreno, “en el laboratorio se venían realizando actividades de biología molecular para el estudio de microorganismos con nivel de riesgo poblacional bajo (grupos de riesgo 1 y 2), exclusivamente con fines académicos e investigativos, es decir que no somos ajenos a los protocolos, pero solo tenemos capacidad instalada para procesar unas 20 pruebas diarias. Con la adecuación y compra de los equipos requeridos podríamos llegar a 200 diarias y cerca de 60 mil anuales”. Lo que se espera luego de las adecuaciones es obtener el aval para prestar el servicio a la comunidad.
La institución también cuenta con un grupo cualificado de científicos e investigadores, quienes, además de diseñar y aplicar las pruebas, pueden ejecutar estudios epidemiológicos para la identificación de factores de riesgo asociados con enfermedades transmisibles y ofrecer datos significativos sobre su comportamiento y desarrollo, para que los tomadores de decisiones planeen acciones adecuadas que contrarresten sus efectos, los mitiguen y controlen.
En esta alianza académico-científica, la Universidad logró la articulación de un equipo interdisciplinario de docentes investigadores, adscritos a las líneas de trabajo: Enfermedades Infecciosas, Salud Pública y Bioingeniería y TIC.
En el laboratorio de investigaciones de ciencias de la salud de la UPB, ubicado en el campus Robledo, trabajan los grupos de investigación en Biología de Sistemas, coordinado por la doctora en Biología, Isabel Cristina Ortiz Trujillo, y en Salud Pública, coordinado por Lucelly López López, doctora en Gestión de la Tecnología y la Innovación.

La Red Regional de Laboratorios estará conformada por:
- Laboratorio Departamental de Salud Pública de Antioquia
- IPS Universitaria - Institución Prestadora de Servicios de Salud de la Universidad de Antioquia
- Universidad de Antioquia
- Universidad Nacional de Colombia, sede Medellín
- Instituto Tecnológico Metropolitano - ITM
- Universidad EIA
- Instituto Colombiano de Medicina Tropical - ICMT
- Universidad de Medellín
- Universidad Eafit
- Universidad Pontificia Bolivariana - UPB
- Corporación Universitaria Lasallista
- Universidad Cooperativa de Colombia
- Corporación para Investigaciones Biológicas - CIB
- Institución Universitaria Colegio Mayor de Antioquia
Por Luisa María Echeverry. Programa de Divulgación Científica – Agencia de Noticias UPB.